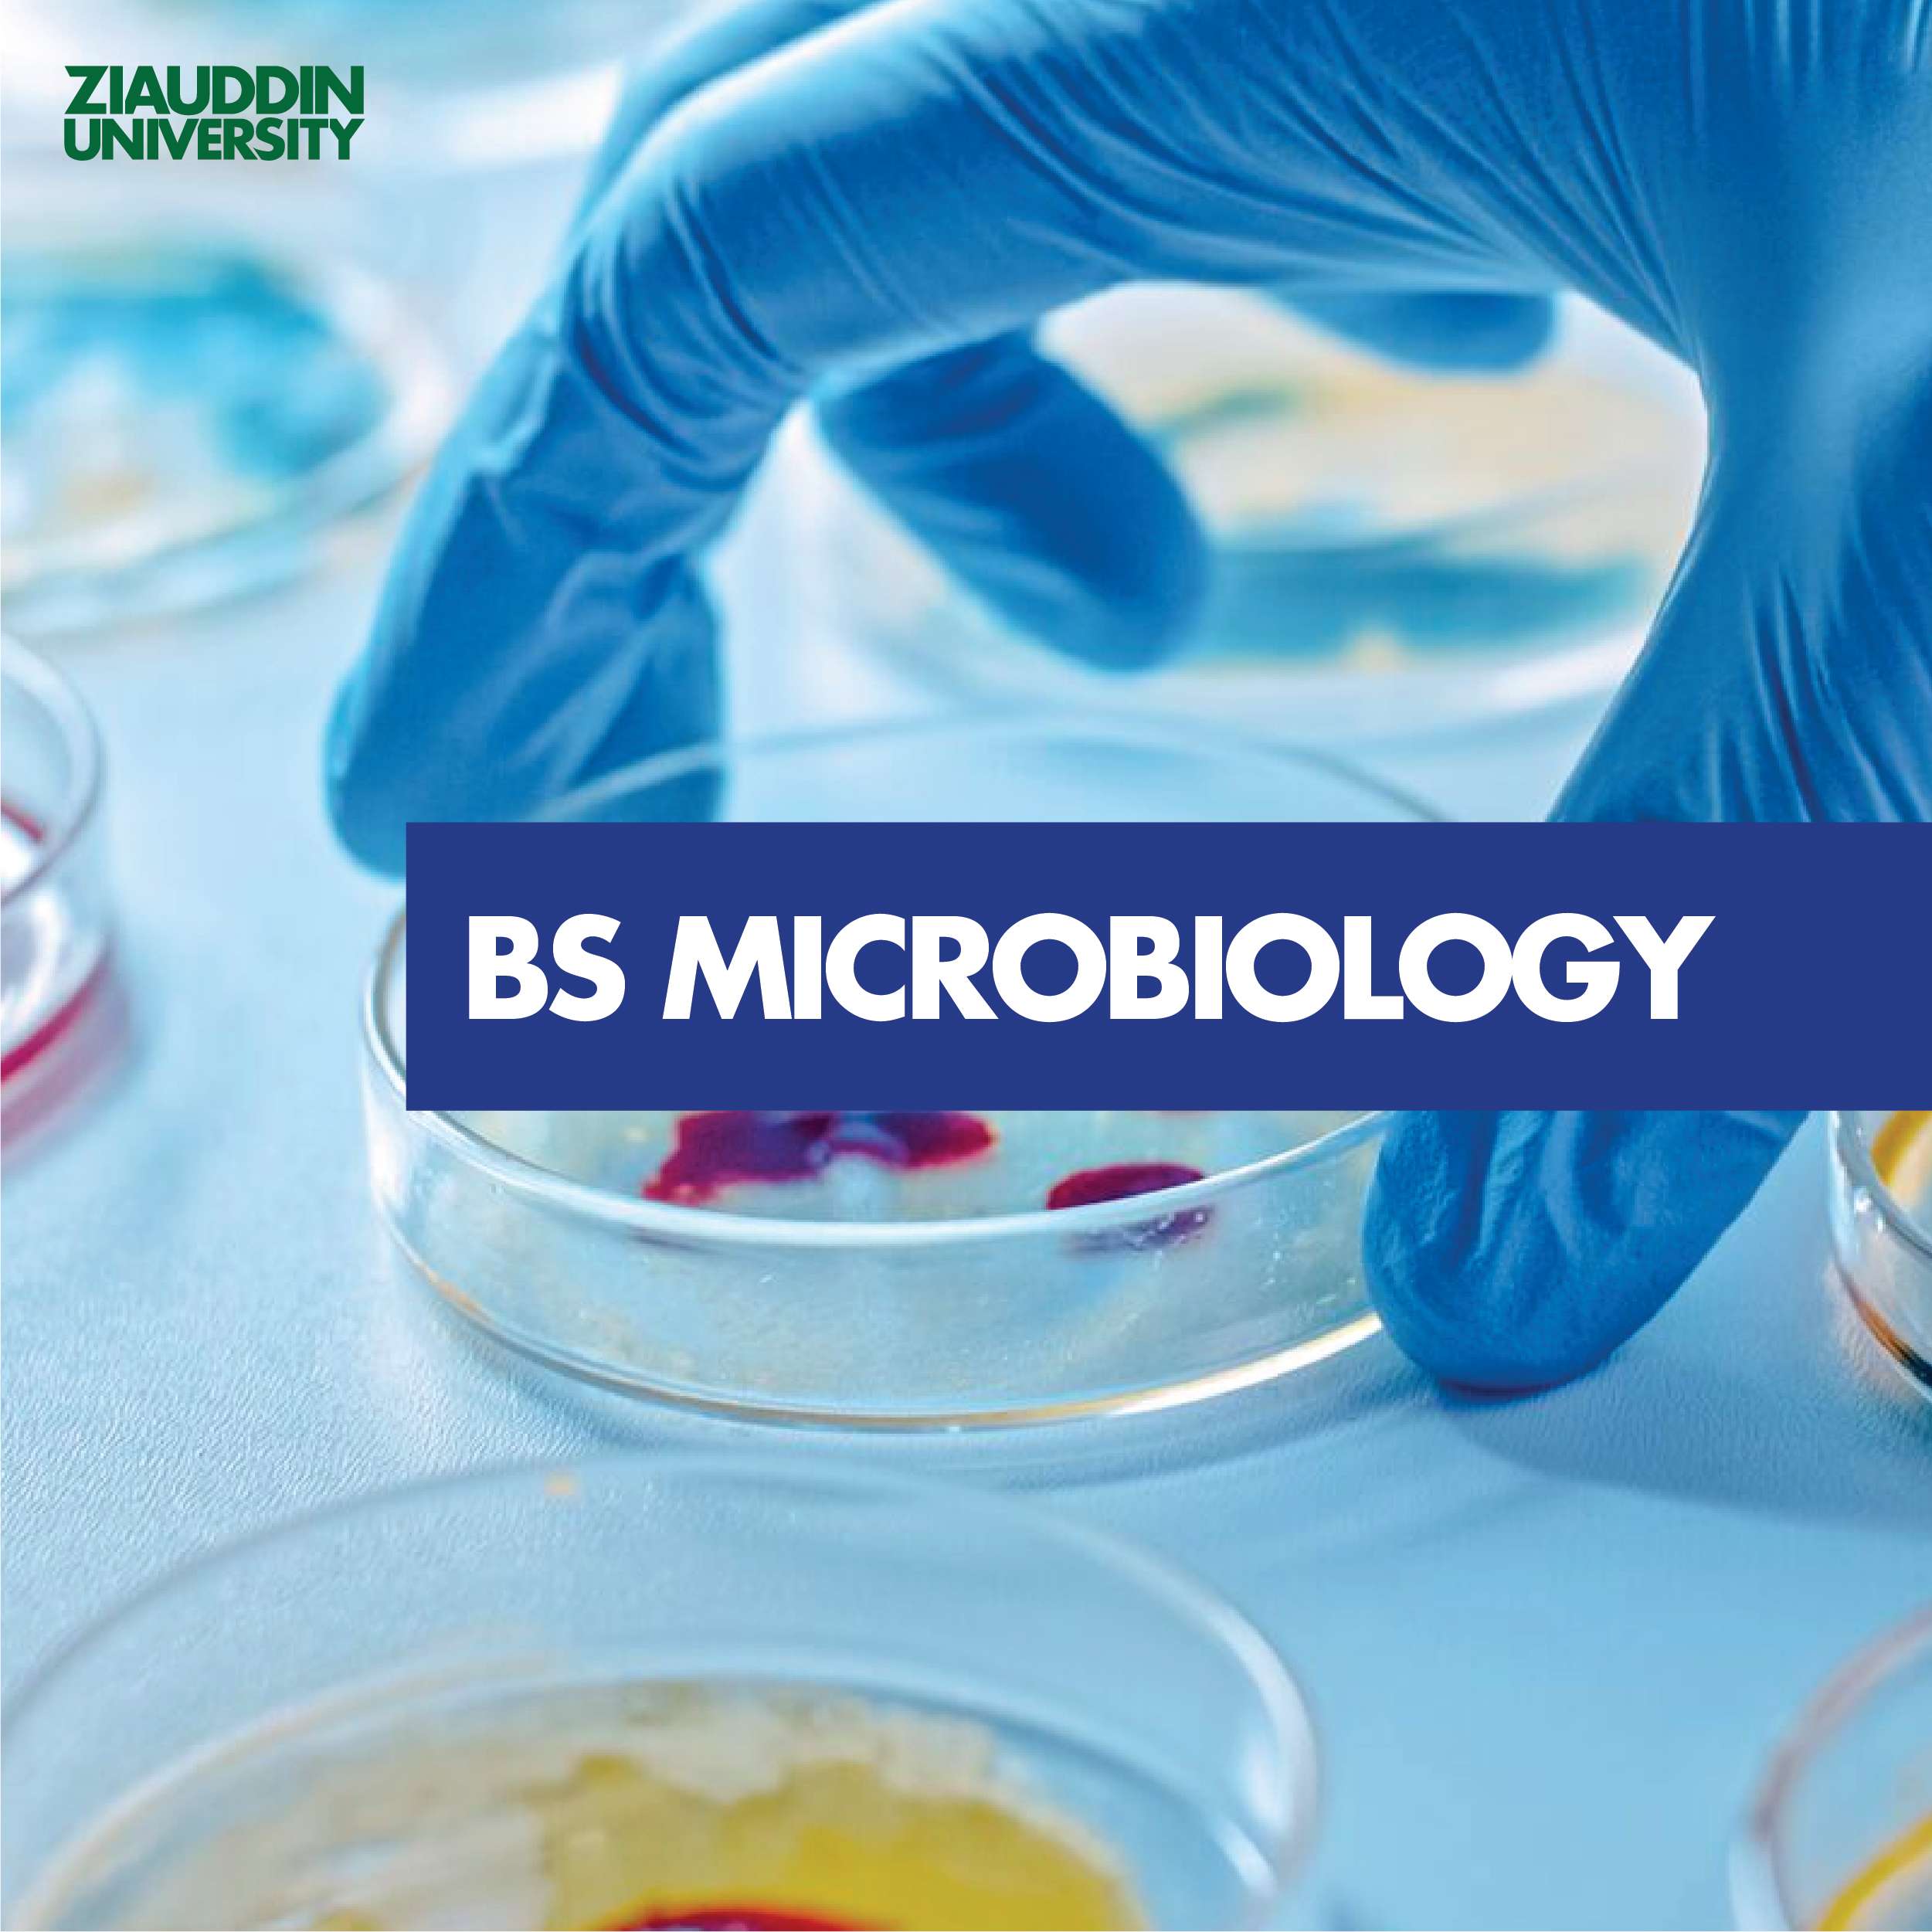

Ziauddin University, Faculty of Engineering Science and Technology is offering 4 years bachelor program entitling BE Biomedical Engineering at Ziauddin University, Biomedical Engineering is more focused on the instrumentation and biomedical computing. The instrumentation or more formerly Bio-Instrumentation is the field for travel enthusiastic person, as the installation, sales and service of the biomedical instruments. It keeps the engineers on the wheel, in order to maintain the instruments operational for the patient support in hospitals, pharmaceutical industries and healthcare laboratories. Moreover, the instrumentation track of Biomedical Engineering also serves humanity by developing assistive devices for patients and elderly people. The patient can wear the robotic suits, also known as exo-skeleton. These suits assist the wearer in achieving the mobility they lost due to disease, trauma or age factor. Also, the development and rehabilitation of artificial limbs lies under the umbrella of instrumentation track. The emerging focused area of Biomedical Engineering at ZUFEST shall be Biomedical Computing. The biomedical computing facilitates the development of complex biomedical systems like clinical and computer-based decision support, knowledge acquisition and management, medical imaging, computational intelligence in bio-clinical medicine, molecular medicine, and healthcare organizational aspects. It implies the use of Artificial intelligence for the purpose of machine learning, bioinformatics for genes and protein modeling, and Medical Image Processing. In order to incorporate these skills with the knowledge of the students, Biomedical Engineering at ZUFEST introducing Telemedicine system, Computational Fluid Dynamics, Bioinformatics, and Hospital information system. Five batches of Biomedical Engineering have been successfully passed out and accredited by PEC, and almost all the students are well placed at suitable biomedical jobs in the market. The curriculum is in line with HEC/NCRC.
Department of Biomedical Engineering
- Introduction
- Undergraduate
- Postgraduate
Vision
To become a top tier Department of Biomedical Engineering across the nation by imparting engineering knowledge to serve health care industry with excellence.
Mission
The Department of Biomedical Engineering aims to serve the society in the best manner wherein the graduates will be equipped with required technical and interpersonal skills, motivated for research and lifelong learning; ethical values along with leadership and entrepreneurship qualities.